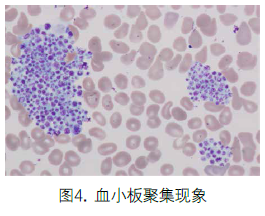
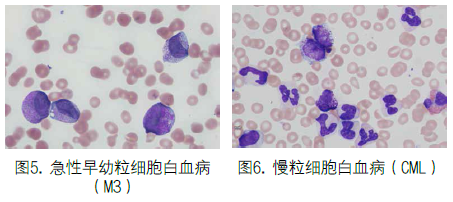
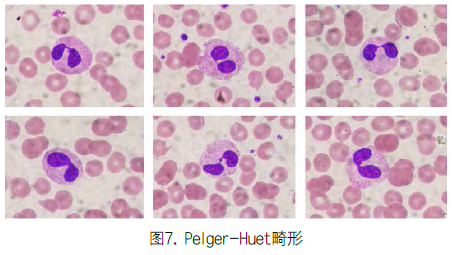
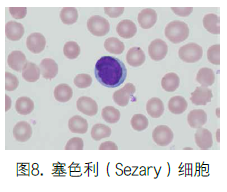
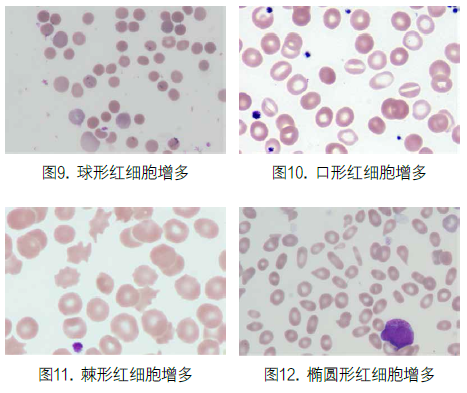
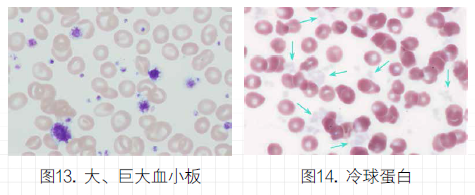

应用血细胞分析仪应关注的复检要点
2021-4-29 16:48|
编辑: 沙糖桔|
查看: 3910|
评论: 0|来源: 临床实验室
摘要: 在应用各种血液细胞自动化分析设备时,复查和复检很重要,我们应该从下面几点进行复查或者复检,及时发现问题。

由于血细胞分析仪具有快速、准确和便捷等优势,60多年来一直在改变实验室血常规检验方法与检验流程。近年来血细胞分析仪由于各种新技术的使用,其检测性能越来越强大,检测参数也越来越多,特别是具有白细胞五分类技术的仪器的普及应用及全自动流水线化的血细胞分析系统的使用,使得实验室越来越依赖这样的设备来完成大量的血常规检验工作[1]。在样本量加大和人员缺乏这种特定环境条件下,外周血涂片检查的重要性被逐渐淡化和忽视,以至造成一些漏诊与错误。这种现象已经引起国内外临床检验界的重视,因此P.W.Barnes等教授倡导并组成了国际血液学复检专家组(International Consensus Group for hematology Review),并在2005年制定了自动血细胞计数和白细胞分类计数的复检标准[2],该标准被国际实验血液学学会(ISLH)作为一个推荐方法介绍给全球使用各种自动化血液分析系统的专业人士参考。中华医学会检验分会也于2006年组成全国血液学复检专家小组对该标准进行了标准的释义并将其发表[3],这就是我们所熟悉的41条筛检规则。而采用不同的血细胞分析系统,建立与各自医疗单位和服务人群相适应的复检规则也成为血液分析仪的用户单位的重要工作,这也是卫生部实验室管理办法和ISO 15189评审中重要的检查条款。在应用各种血液细胞自动化分析设备时,复查和复检很重要,我们应该从下面几点进行复查或者复检,及时发现问题。进行血细胞分析复检时,首先应该关注标本的性状非常重要。明显影响检测结果的问题包括:标本采集量是否符合要求,血液标本凝集或有凝块,乳糜血或脂血,冷凝集现象或冷球蛋白,溶血,高白细胞血症,高胆红素血症等。1.标本采集量:如果使用真空采血管,采用真空采血模式,一般不会出血采集量差异太大的情况。但遇到抽血困难,或许有采集量不足问题。此时应与临床沟通,确认检验结果是否受到影响,如果没有受到影响,采用让步检验的模式发放报告,并备注说明采集量问题。如果用注射器采集后注入采血管内,会发生采集量不准,过少或者过多。过多时可能造成抗凝剂与血液比例不适,导至抗凝不充分,从而影响血小板及其他指标的检测结果,此时应做不合格标本处理。2.凝血标本:通过肉眼观察可以发现标本已经凝血;摇动试管可以发现试管内有大小不同的凝块;打开试管帽可见管帽内存有凝块;用长竹签或施工搅动标本或吸取,用于发现肉眼没有发现的凝块或纤维蛋白凝丝。此类标本可判定为不合格,应予拒收退回。3.乳糜血或脂血:通过自然沉淀或离心沉淀,可发现乳糜血(图1),乳糜血会导至光学法检测的HGB测定结果不正确,进而影响MCH,MCHC计算结果,此时需采用离心置换血浆的模式排除干扰后再行测定HGB,或者采用光学法原理的仪器或功能测定HGB结果,并重新评估和计算MCH,MCHC。高脂血症肉眼不可发现,可通过LIS系统查询生化检测结果,再查看WBC分类散点图,评估分类结果是否正确,必要时应采用显微镜分类法纠正白细胞分类结果。4.冷凝集及冷球蛋白:严重的冷凝集现象肉眼可见试管壁出现细沙样颗粒(图2),弱冷凝集时可将标本置于4°C冰箱环境下3-5min,即可肉眼发现,也可将少许标本滴于玻片上在显微镜下查看。冷凝集现象可导至红细胞测定结果偏低,进而导至MCH,MCHC计算错误,MCV测定不准确,兼而影响WBC计数不准确。应首先采用37°C水浴30~60min之后再行测定的方式解决。冷球蛋白极难发现,往往导至PLT结果假性升高,通过血涂片和散点图异常可初步发现,最终需要通过免疫固定电泳或毛细管免疫分型结果来确定。此时PLT结果不可轻易发放,或许要经37°C水浴30~60min之后再行测定,排除冷球蛋白干扰。5.溶血:将标本离心可发现是否有溶血现象,如有溶血则可作为不合格标本拒收。6.高白细胞血症:白血病患者白细胞往往会升高至100×109/L以上,一般认为当白细胞数量>200×109/L时会导至比色法HGB测定结果不正确,严重贫血患者甚至还会影响到RBC检测结果的准确,进而影响MCH,MCHC计算结果的正确。将标本沉淀一段时间就可以看到红细胞层与血浆之间出现明显的白细胞沉淀层(图3)。可通过HGB、RBC、HCT之间的关系和MCH、MCHC的结果综合判定分析,确认该血常规结果是否符合规则,一旦影响应减除白细胞数量对红细胞的影响以及HGB受到的浊度干导至的错误,进行纠正后再发报告。高白细胞血症(特别是中性粒细胞)还可影响血糖检测结果,导至其降低[10],应及时与科室负责血糖检测的同事进行沟通交流。
7.高胆红素:高胆红素可通过沉淀或离心法,观察血浆颜色进行初判,更可通过LIS系统查阅血清Bil测定结果后判定。高胆红素时会导至比色法的HGB结果偏高,进而导至MCH、MCHC计算结果不准确,也可通过这两个计算参数的异常来评估标本是否受高胆红素影响而导至偏高。如遇到此问题,可采用置换血浆的方法重新测定HGB结果,并纠正HCH、MCHC计算结果。8.其他:包括标本采集错误,无条码或标签、标签脱落、试管破裂、试管盖未盖紧导至标本渗漏等问题,应予以拒收。这一点很重要!血涂片的复检与复核方法有两种,血片浏览(review)和血片分类(differential)。许多情况下我们仅仅需要浏览复核血片,用于确认血细胞分析仪得出的结论,例如红细胞体积大小(对发现的红细胞异常形态、染色、内含物应同时进行描述和报告),大小不等、某类细胞增高或减低(不包括形态学报告内容)。对出现白细胞形态学提示的问题,分类不正确的问题、不能分类的问题,则应采用显微镜下血片分类,重新分类报告。那么复检规则要关注和解决哪些问题呢?以下几点建议供参考:1.首先浏览血涂片,此时可采用低倍(或高倍)镜浏览观察,初步了解血涂片制片效果,细胞的分布情况,染色效果,有否具有病理意义的大型细胞的出现等。如果是EDTA抗凝血,血小板应该分布均匀,不应出现聚集现象,如有出现明显的血小板聚集现象,特别是在玻片的两端和尾部出现大片凝集时(图4),将是导至仪器法计数血小板假性减低的重要原因,也是复检时首先要关注的问题,也是检验科最不应该漏检的内容。观察血片同时还需要观察红细胞的分布与排列,发现缗钱状排列现象和红细胞凝集现象等,从而发现初步判断是否有多发性骨髓瘤、巨球蛋白血症、血粘度较高或者冷凝集综合征等,甚至考虑判断是否会影响红细胞计数的准确性等问题。
2.通过血涂片的浏览观察,可以对血细胞分析仪测定的细胞计数结果进行复核,初步评估仪器计数结果的可靠性和一致性。例如白细胞可参考表1的关系进行复核[4];或采用估算方法进行复核,选择血片中分布均匀的区域进行评估,白细胞计数(×109/L)=每高倍镜视野中白细胞平均个数×2×109/L[5]。
还可根据血涂片上血小板分布情况初步评估仪器对血小板计数结果的一致性及复核。如果每油镜视野中平均1个血小板,相当于PLT计数结果的10×109/L,依次类推。或者通过血片推断血小板数量,选择血片体尾交界处分布均匀、无异常聚集或纤维蛋白丝的区域,浏览血涂片可大致估算血小板数量,方法为:血小板数(×109/L)=每油镜视野中血小板平均个数×15×109/L[5]。3.复检中很重要的问题是不要漏检血液系统疾病(图5、图6),特别是血液系统肿瘤。虽然许多品牌的血细胞分析仪可以给出不成熟粒细胞(IG)、异型淋巴细胞(ATYP)、原始细胞(BLAST)、核左移(LEFT SHIFT)、大型未染色细胞(LUC)等提示性报警信息,甚至是数量结果信息,但是他们依然具有局限性。根据目前的技术水平,五分类原理的血细胞分析仪尚不能对多种异常细胞给出明确的定义,更谈不上对血液系统疾病给出正确的白细胞分类报告。因此需要有经验的检验医师或技师进行细致的显微镜分类复检。我们在进行显微镜涂片检查时,除了关注和发现各系原始或幼稚细胞外,此外还应关注白细胞内的颗粒变化,如多颗粒中性粒细胞和少(乏)颗粒中性粒细胞;中性粒细胞毒性改变,如中毒颗粒(也称多颗粒中性粒细胞)、空泡变性、Döhle小体及白细胞体积大小不均等;核左移与核右移;Pelger-Huet畸形(图7)、May-Hegglin畸形、Chediak-Higashi畸形、是否吞噬病原微生物等现象。这些问题的出现对诊断传染性疾病、某些严重感染、中毒、恶性肿瘤、猩红热、白喉、MDS等具有重要意义,还对疾病的治疗和预后判断具有一定的帮助。对嗜酸性、嗜碱性和单核细胞异常增高的病例,也需进行镜下复核与确认,以防止出现假性增加的问题。此外还要观察是否有其他异常细胞出现,如异型淋巴细胞、浆细胞、骨髓瘤细胞、毛细胞、塞色利(Sezary)细胞(图8)、淋巴瘤细胞等,以便初步筛查某些血液系统疾病。白细胞参数出现异常报警提示,一般要考虑进行显微镜下的白细胞分类,将幼稚或异常的白细胞给出适当的百分比报告,对仪器分类错误的结果要给予纠正或重新分类确定。如果某些报警信息过于敏感,经镜检确认未见异常报警信息所提示的细胞、或未见异常细胞,也要在报告中予以记录和说明。

4.应该关注红细胞形态信息,提供贫血诊断的初步鉴别信息。一般血细胞分析仪都会提供许多红细胞报警的信息,如大细胞(Macro)、小细胞(Micro)、红细胞大小不等(Aniso)、血红蛋白含量不均(HC VAR)、低色素性(Hypo)、高色素性(Hyper)等形态学信息。作者认为这些红细胞形态学信息是更加准确的告知一个样本的红细胞大小或大小不等的信息,他更加客观、更加敏感,更加准确的、定量化的了解红细胞大小及色素改变的情况,是比较可信的参数,而这些参数的准确性应该建立在仪器校准合格、仪器质控在控及MCV\MCH\MCHC三项浮动均值指标完全在控的基础之上。而人工观测和描述这些红细胞信息,则可能受到个人经验因素影响,作者认为其敏感性和一致性不如仪器分析结果准确和稳定。红细胞大小及形态学改变的临床意义参见表2。
红细胞分析还可对一些现象进行提示性报警,如红细胞聚集(RBC Agglutination)表示标本可能有冷凝集现象;HGB测定浑浊增加(HGB Interf)则可能是因乳糜血因素的影响;有核红细胞增加(NRBC)、红细胞双峰分布(Dimorphic Pobulation)、红细胞碎片(RBC Fragment)干扰等,这些提示可以对一些红细胞和血红蛋白异常现象进行初步判断,但是NRBC、红细胞聚集、红细胞碎片现象等还需要进行显微镜下的确认。如果这些现象出现,会影响到白细胞和红细胞计数的正确性,进而影响红细胞相关计算参数的准确性,因而需复检血片;红细胞碎片增多会干扰阻抗法的血小板计数结果,也要通过仪器直方图和散点图初筛,通过复检血片而确认,并且需要对受到影响的计数结果进行纠正。我们复检血片所需要关注的是许多红细胞形态的异常改变、染**况和内部结构出现异常时,血细胞分析仪的有关参数和报警信息不能完全覆盖或不能正确提示,如珠蛋白生成障碍性贫血和HbC时出现的靶形红细胞;遗传性椭圆形红细胞增多症;自身免疫性溶血性贫血时的球形红细胞(spherocyte)增多(图9);肝脏疾病、溶血性贫血和小儿消化系统疾病导至的口形红细胞(stomatocyte)增加(图10);舞蹈病和重度肝损伤时的棘形红细胞(acanthocyte)增多(11)、骨髓纤维化时的泪滴样红细胞(tear drop)、巨幼细胞贫血和椭圆形红细胞增多症时的椭圆形红细胞(elliptocyte)增加(图12);以及镰状细胞(sickle cell)贫血、嗜碱性点彩(basophilic stippling)红细胞、卡波环(Cabot rings)和豪焦小体(Howell-Jolly bodies)等情况出现和增加,均需要通过观察红细胞形态而进行识别和参与临床辅助诊断。
2015年,国际血液学标准委员会(International Council for Standardization in Haematology,ICSH)根据十多位专家的研究和建议,推出了有关红细胞形态术语的标准化和外周血细胞形态学特征分级标准(ICSH recommendations for the standardization of nomenclature and grading of peripheral blood cell morphological features),见表3。该项推荐标准对今后应用细胞形态术语的标准化,特别是在判断细胞形态异常的标准方面,提供了有价值的借鉴性指导[6]。其中有关红细胞形态的术语和分类原则,与我国专业书籍或教科书中有关红细胞形态的命名及分类原创有一定差距,这方面应该引起我国同行们的注意。同时笔者也建议国内检验学会和血液学专家尽快讨论,制定或建立中英文标准化术语和译名,规范化各种细胞类别的定义,这对专业的发展是有积极意义的。
5.特别关注血小板,血小板体积小,易发生聚集和计数不准,因此是非常容易出现问题的复检内容之一。在进行血涂片检查或复检时,首要注意是否出现血小板聚集(PLT Clump)报警信息,或者血小板分布异常(PLT Abn Distribution)的提示,特别是应用EDTA抗凝血标本时,注意防范血小板假性减低现象发生。而EDTA抗凝剂导至的假性血小板减低会给临床带来误诊或延误治疗。此外还需要关注大血小板是否明显增加的报警(Large PLT),它会使阻抗法计数的血小板出现假性减低现象,此时需要考虑是否改用其他检测原理的设备,或者改用显微镜计数法进行纠正,巨、大血小板出现过多甚至会导至仪器“漏数”,这些超出红细胞体积大小的巨、大血小板只有通过镜检才能发现(图13)。外周血出现较多颗粒缺失或减少的血小板、巨大血小板、形态异常的血小板、血小板体积明显大小不等,对骨髓病态造血相关的疾病和凝血机能障碍的疾病具有提示意义,如骨髓增生异常综合征、慢性骨髓增生性疾病等。此外作者在最近的两年中还发现了冷球蛋白血症患者,导至血小板计数假性升高的病例,如果是假性升高到极高的水平(如>1000×109/L)通过我们的复检规则还可以发现,如果是血小板偏低,而假性升高到正常水平,甚至仪器不出现任何报警信息,那则是非常难以发现和复检查出的,可间接通过镜检血涂片,注意发现红细胞之间的不规则形的蛋白凝聚形成的凝固痕迹,同时评估血小板数量与仪器计数结果是否符合,如果不符合,特别是仪器计数结果显著增高,可以怀疑为冷球蛋白现象的干扰。我们在2013和2015年就发现两例此类患者。因此发现冷球蛋白血症,其血小板计数结果一定要经过人工复检来确认,这是以前的复检规则中未曾提到的问题[7]。
6.血片检查中另一特别需要重视的问题是血液寄生虫,某些患者可能因临床症状不典型,未引起临床医生关注寄生虫感染问题。我们在血液中可以发现疟原虫[8]、微丝蚴、巴贝斯虫、锥虫、弓形虫等感染,要知道这些病原体的发现,实际上是给临床出具了诊断性报告,是血液检验中可以发出确诊报告的项目,这是非常重要的。如果临床病人有相关症状,或临床医生提示检查血液寄生虫,应将血片仔细浏览,或者多涂几张血片,包括厚血片进行细致检查。而目前在南方,特别是从疫区国家归来的人员,其疟原虫感染率非常高,值得警惕和仔细检查。
复检有时候还需要传统的显微镜法予以配合,虽然血细胞分析仪在计数的准确性、精密度上、检测速度上已经大大高于传统的人工测定方法,是毋庸置疑的。但是在某些特定的病例上,可能还需要人工法予以验证和辅助分析。假如遇到EDTA及枸橼酸钠抗凝剂均可引发血小板聚集的病例,就需要回归显微镜计数法。遇到严重的冷凝集现象或者冷球蛋白血症、红细胞碎片增加的病例,都有可能导至红细胞计数及血小板计数出现错误,都可能要回归显微镜计数法予以解决。溶血性贫血患者过高的网织红细胞,也可因仪器试剂或线性问题导至计数结果偏低或不正确,且在41条规则中并未涉及到此类问题的复检规则,因此也需要用传统的煌焦油蓝染色和显微镜计数法予以纠正[9]。在41条复检规则中也多次提到重复和复查,并用重测标本、稀释标本后重新测定、替代方法计数、按实验室SOP进行等。这是触发某条规则后,需要实验室采用复查、稀释标本复查或其他方法进行验证与确认。重测标本:当遇有相关问题时,可采用重测标本的方式确认,最好用另一台仪器,甚至另一品牌或不同原理的仪器进行重复,将有助于发现问题(前提是实验室内仪器均应进行室内比对并符合比对要求)。稀释标本后重新测定:当计数结果超出实验室设定的线性范围时,应采用稀释后测定的方法获得更加准确的结果。推荐用仪器配套的鞘液或稀释液进行定量稀释,记住稀释比以便计算最终结果。替代方法计数:实验室应确认采用传统计数方法对仪器不能准确测定的某些标本进行核实和计数。实验室应该制订适当的SOP,并准备适当的器材和试剂。作者建议实验室内血小板稀释液、白细胞稀释液、煌焦油蓝染液等应该是首选必备的试剂(图17)。
目前已经有数字图像的血细胞检查系统,这些数字图像设备甚至可以配置到血细胞分析仪流水线上,全自动运行。系统会按照实验室制订的复检规则存入系统,当样本触发复检规则后,设备可自动将血液运输到涂片染色设备,制作一个标准的血涂片。再将血涂片置于自动显微镜下进行数字图像拍摄,然后数字识别软件对白细胞进行分类处理。其完全模拟显微镜分类技术进行形态学血细胞检查,这是一个有益的进步。但是可能还有一些瓶颈问题尚未得到解决,或许因血细胞形态千变万化,在原始和幼稚细胞、异常细胞形态等方面,在某些成分的干扰情况下,其正确识别率仍有待进一步的提升。目前对应用此类仪器应用,作者的建议是,首先进行屏幕审核,纠正其错误识别的细胞,消除干扰成分,对难以鉴别的样本,重新进行显微镜下的观察和判别。
目前在广泛应用各种品牌的自动化血细胞分析仪进行大量血常规标本检测的背景下、在工作量增加、检验人员配备不足、检验报告时间被限定的现实条件下,制定适合自己实验室使用的、能够保证实验质量、尽量减少漏检和实验误差的复检规则,非常重要。更为重要的是有了复检规则、应该具体落实和执行这些规则,不要流于形式,以保证实验室所出具的报告具有可信性和高质量,最大限度的满足临床医师诊治工作对临床检验的需求。注:本文来源于《临床实验室》杂志2021年第4期“临床检验”专题
|
声明:
1、凡本网注明“来源:小桔灯网”的所有作品,均为本网合法拥有版权或有权使用的作品,转载需联系授权。
2、凡本网注明“来源:XXX(非小桔灯网)”的作品,均转载自其它媒体,转载目的在于传递更多信息,并不代表本网赞同其观点和对其真实性负责。其版权归原作者所有,如有侵权请联系删除。
3、所有再转载者需自行获得原作者授权并注明来源。
 /3
/3 